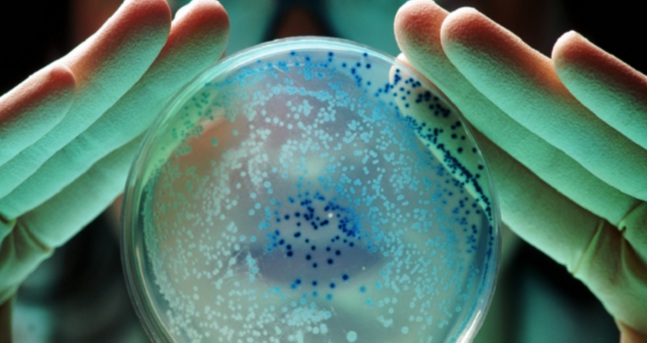

ايجى ٢٠٣٠ / وكالات
أجرى فريق من العلماء دراسة حديثة لفحص مستويات التلوث بالبكتيريا والجراثيم في الأماكن والأشياء التي يتفاعل معها المسافرون يوميا خلال تنقلاتهم.
واكتشف فريق البحث أن عجلات حقائب السفر هي من أكثر الأدوات تلوثا بالبكتيريا، حيث تحتوي على كمية من الجراثيم تفوق تلك الموجودة على مقاعد المراحيض العامة بأربعين مرة.
وفي الدراسة، فحص الفريق نحو 10 حقائب سفر في مركز قطارات بمطار لندن، حيث أُخذت مسحات من عجلات وقواعد الحقائب ذات الغلاف الناعم والصلب.
وأظهرت النتائج أن عجلات حقائب السفر تحمل حوالي 400 مستعمرة بكتيرية لكل 3 سنتيمترات مربعة، وهي مساحة أصغر من بطاقة ائتمان، ما يجعلها أكثر تلوثا من مقعد المرحاض العادي، الذي يحتوي عادة على حوالي عشر مستعمرات بكتيرية.
ووُجد أن هذه الجراثيم مرتبطة بمخاطر صحية مثل التسمم الغذائي والالتهابات ومشاكل الجهاز التنفسي. كما بيّنت التحاليل أن حقائب السفر ذات الغلاف الناعم تعد أكثر تلوثا، لأنها تحتفظ بالرطوبة والأوساخ، ما يعزز نمو العفن.
وما يثير القلق أن كثيرا من المسافرين يضعون هذه الحقائب الملوثة على أسرّة الفنادق وطاولاتها ورفوف خزائنها، ما يزيد من احتمالية انتقال الجراثيم إلى أماكن نظيفة.
وكشفت الفحوصات عن وجود بكتيريا مثل المكورات العنقودية الذهبية وجرثومة Serratia marcescens وبكتيريا Bacillus cereus، بالإضافة إلى فطريات العفن المعروفة كالرشاشيات السوداء والبنسليوم. كما تم العثور على بكتيريا الإشريكية القولونية التي تشير إلى تلوث برازي، ما يعني أن العجلات تلتقط أوساخا من دورات المياه أو الأرصفة.
وحذرت عالمة الأحياء الدقيقة إيمي ماي بوينتر، قائدة الدراسة، من أن هذه الميكروبات متنوعة وتعكس الأماكن التي وُضعت فيها الحقائب، موضحة ضرورة إبعاد الحقائب عن الأسطح النظيفة وتنظيفها بانتظام.
وشدد الخبراء على ضرورة عدم وضع الحقائب على الأسرّة، ويُفضّل وضعها على رف الأمتعة أو الأرض، مع مسح العجلات والقاعدة بمناديل مطهرة أو قطعة قماش مبللة بالصابون للحد من تراكم الجراثيم.
وأكدت الدراسة أن هذه الإجراءات الوقائية مهمة للحد من انتقال التلوث والجراثيم إلى المنازل والفنادق، ما يحمي الصحة العامة رغم أن الحقائب نفسها ليست قاتلة.
نشرت الدراسة في مجلة InsureandGo.
المصدر: ديلي ميل





